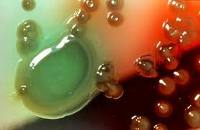
imagesCATYOVTP (1)

La Pregunta es : Sanitizar o Desinfectar
La preocupación por la propagación paulatina de nuevas enfermedades infecciosas, virus y gérmenes hace que el uso de los desinfectantes y sanitizantes se vuelvan más populares que nunca. Con tantas opciones a nuestra disposición y manera de cómo usarse es difícil saber cuál es mejor si un desinfectante o un sanitizante. A continuación podrá ver una guía rápida de referencia.
Definiciones básicas
Los términos de Sanitización y Desinfección a menudo son usados como intercambiables a pesar del hecho de que tienen diferentes funciones porque sus funciones son muy similares.
Desinfectar es el proceso por el cual se remueve cualquier partícula que pueda causar una infección, reduciendo el número de microorganismos presentes. Dicho proceso no quiere decir que elimine por completo los microorganismos presentes, pero los reduce a un nivel en el cual no inicien ninguna infección. En cada desinfectante hay un proceso químico capaz de lograr una desinfección. El proceso de sanitización significa el reducir la cantidad de microorganismos a un nivel de seguridad. Oficialmente un sanitizador puede reducir los microorganismos hasta un 99.999 porciento, esto fue corroborado mediante una prueba científica dentro de un rango de 30 segundos. A diferencia del sanitizante un desinfectante no necesariamente destruye la bacteria que es causante de enfermedades
Desinfectar es el proceso por el cual se remueve cualquier partícula que pueda causar una infección, reduciendo el número de microorganismos presentes. Dicho proceso no quiere decir que elimine por completo los microorganismos presentes, pero los reduce a un nivel en el cual no inicien ninguna infección. En cada desinfectante hay un proceso químico capaz de lograr una desinfección. El proceso de sanitización significa el reducir la cantidad de microorganismos a un nivel de seguridad. Oficialmente un sanitizador puede reducir los microorganismos hasta un 99.999 porciento, esto fue corroborado mediante una prueba científica dentro de un rango de 30 segundos. A diferencia del sanitizante un desinfectante no necesariamente destruye la bacteria que es causante de enfermedades
 Por lo tanto existen diferencias entre un sanitizante y un desinfectante, ya que sus diluyentes son diferentes, ya que un desinfectante necesita un contenido mayor para poder matar las bacterias, comparado con un sanitizante. Por ejemplo el yodoformo usando 25ppm (utilizado el yodo en millones de partes) y es considerado como un sanitizador. Sin embargo este mismo producto cuando es aplicado en un 75ppm es considerado como desinfectante. Quats (compuestos de amonio cuaternario) e hipocloritos son otros ejemplos en los que los cuales la utilización de la concentración del producto define su clasificación. Muy pocos sanitizantes o desinfectantes pueden esterilizar, es decir, eliminar por completo todos los microorganismos, y dependen enteramente de su modo de aplicación.
Por lo tanto existen diferencias entre un sanitizante y un desinfectante, ya que sus diluyentes son diferentes, ya que un desinfectante necesita un contenido mayor para poder matar las bacterias, comparado con un sanitizante. Por ejemplo el yodoformo usando 25ppm (utilizado el yodo en millones de partes) y es considerado como un sanitizador. Sin embargo este mismo producto cuando es aplicado en un 75ppm es considerado como desinfectante. Quats (compuestos de amonio cuaternario) e hipocloritos son otros ejemplos en los que los cuales la utilización de la concentración del producto define su clasificación. Muy pocos sanitizantes o desinfectantes pueden esterilizar, es decir, eliminar por completo todos los microorganismos, y dependen enteramente de su modo de aplicación.
Los desinfectantes son usados frecuentemente (en hospitales, clínicas, cocinas, baños y oficinas) para matar microbios infecciosos, en aéreas donde hay mucho tráfico. Puntos críticos de contacto son baños, lavabos, contario a perilla de puerta, interruptor de luz, cama, barandal, botones del elevador, escritorios, teléfonos, y teclado de computadora.
Desafortunadamente el desinfectante perfecto no existe, debido a que por su naturaleza son potencialmente dañinos para los humanos y animales. Por eso deben usarse con mucho cuidado. La mayoría de los desinfectantes vienen con instrucciones de seguridad y deben ser leídas con cuidado, seguir instrucciones y usarlo con mucho cuidado. Como regla general nunca debe mezclarse con algún otro producto de limpieza ya que puede ocurrir una reacción química.
La opción de utilizar un desinfectante depende de la situación particular. Muchos desinfectantes tienen un amplio grado (matar a casi todos los microorganismos), mientras que otros matan a un rango menor de organismos que causan enfermedades, pero son los preferidos por otras propiedades como los cloruros de benzalconios (por ser no corrosivos, no tóxicos .